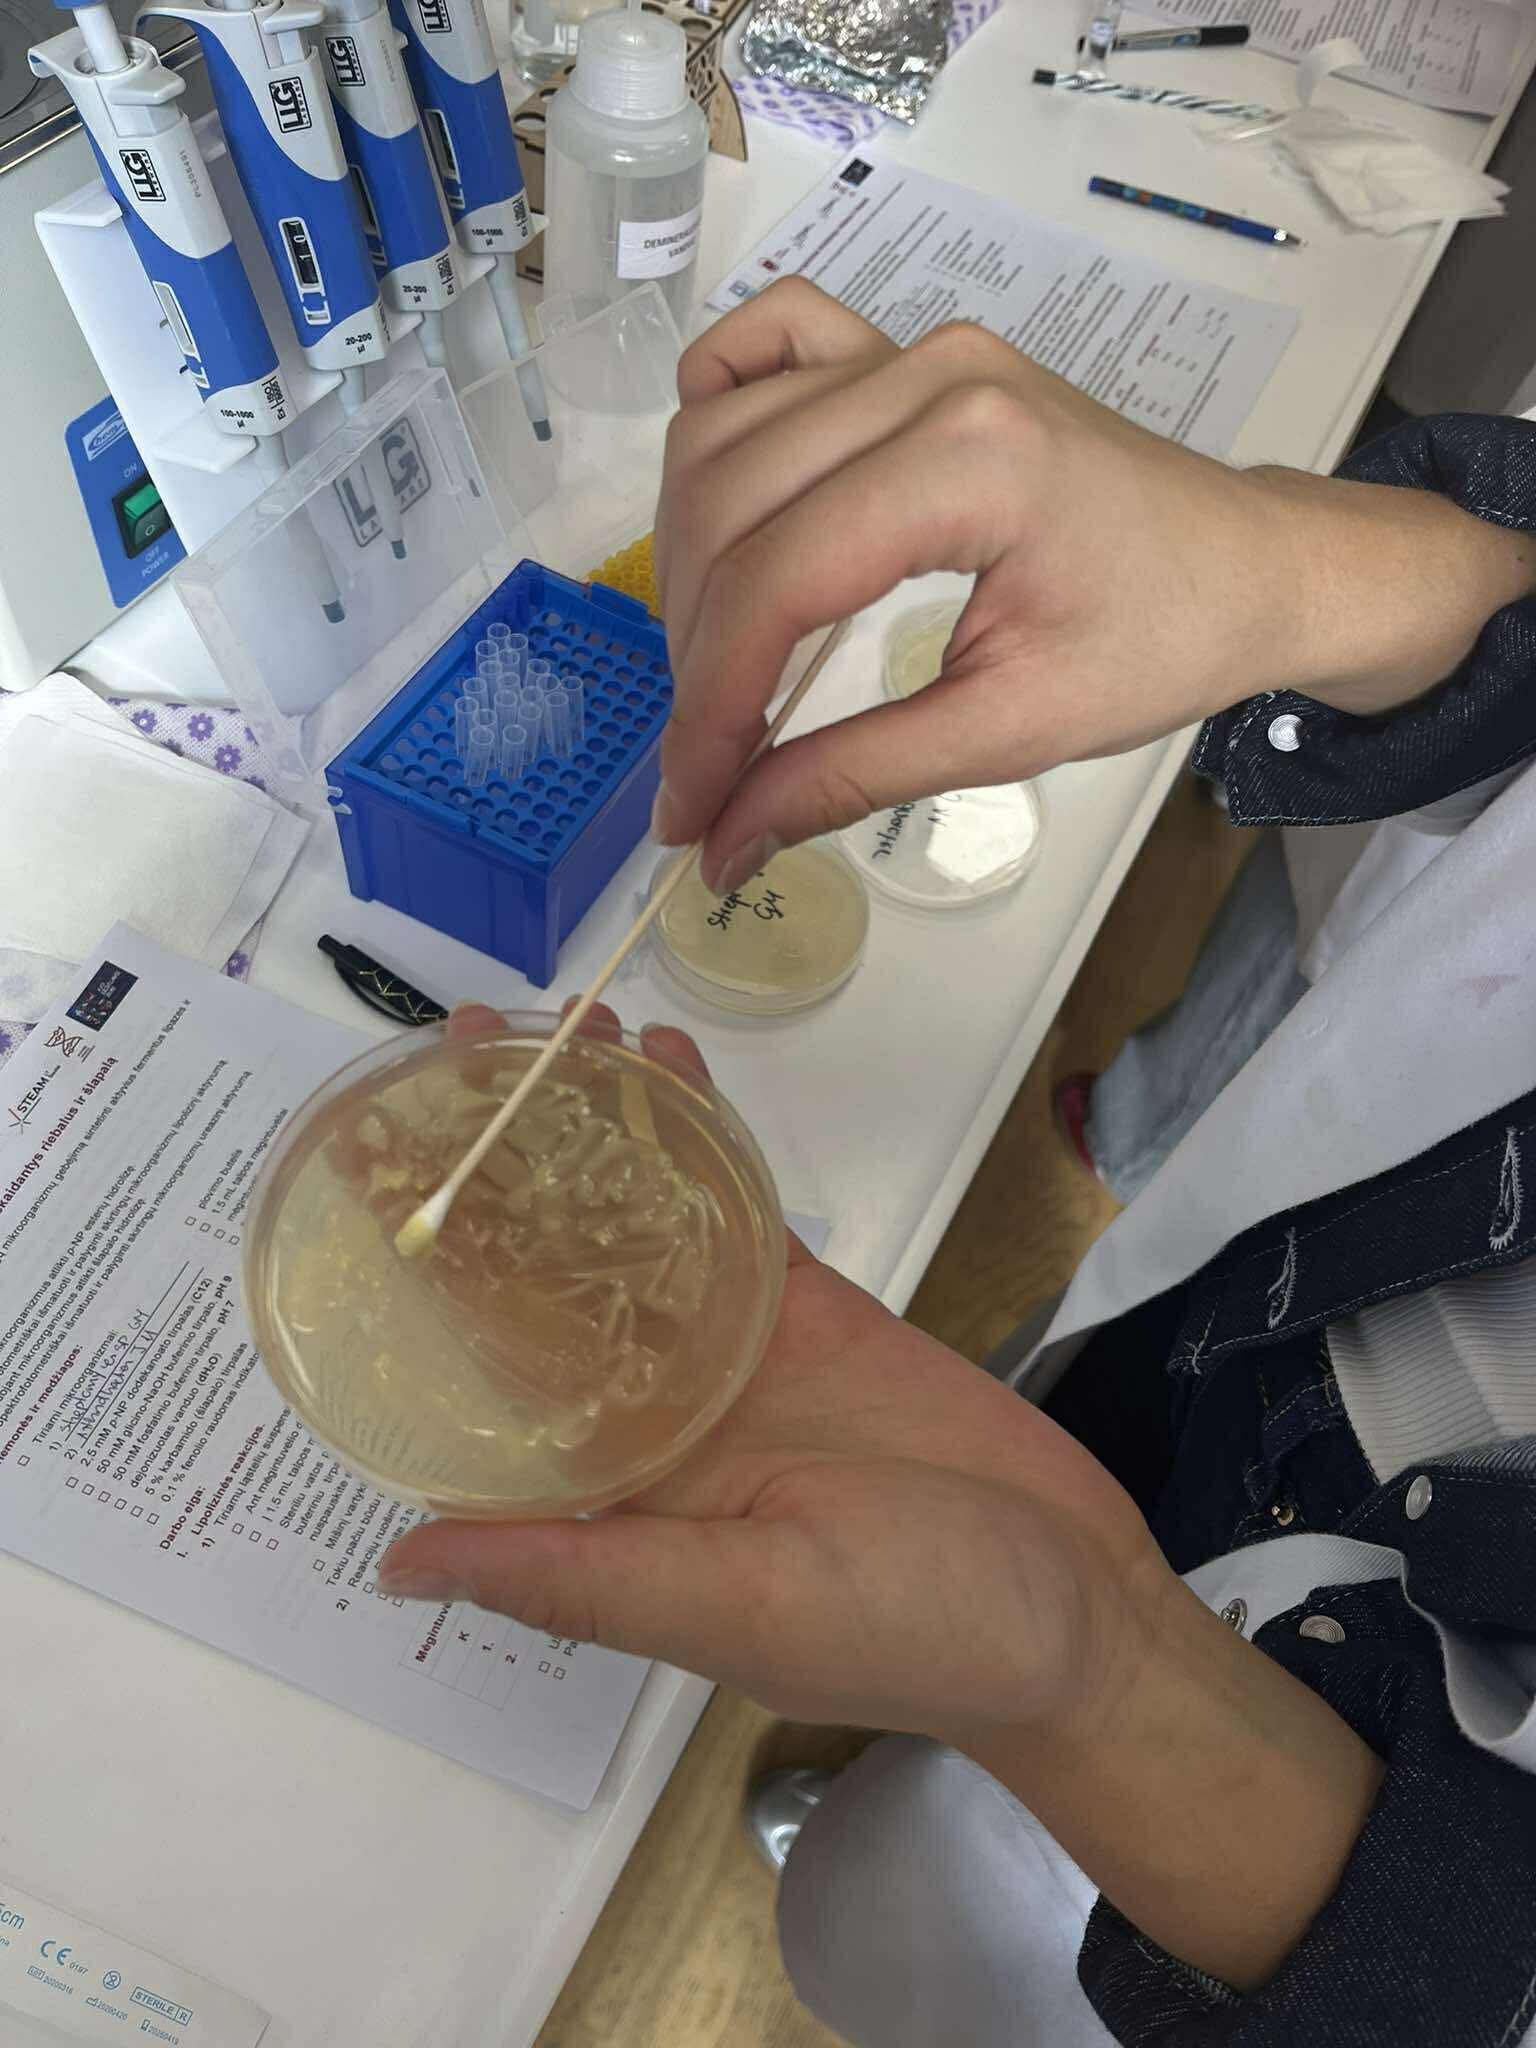

Rugsėjo 11–19 d. Lietuvoje vyksta mokslo festivalis Erdvėlaivis Žemė XXII. Visada į festivalio renginius aktyviai įsijungia ir Didždvario gimnazijos mokiniai. Rugsėjo 17 d. III–IV klasių mokinių grupė dalyvavo Šiaulių STEAM centro užsiėmime „Mikroorganizmų biocheminiai ypatumai“. Šio praktinio darbo tikslas – įvertinti ir palyginti skirtingų mikroorganizmų gebėjimą sintetinti aktyvius fermentus, lipazes ir ureazes.
Atlikdami darbą, mokiniai gilino teorines žinias, kurias vėliau pritaikė praktikoje: ruošė ląstelių suspensijas, jas analizuodami naudojo spektrofometrijos metodą. Mokiniai įgijo naujų įgūdžių, reikalingų sklandžiam bei profesionaliam darbui laboratorijoje. Džiaugiamės turėję galimybę atliktį šį praktinį darbą.
Martynas Skiutė, IVd kl. mokinys
![]()